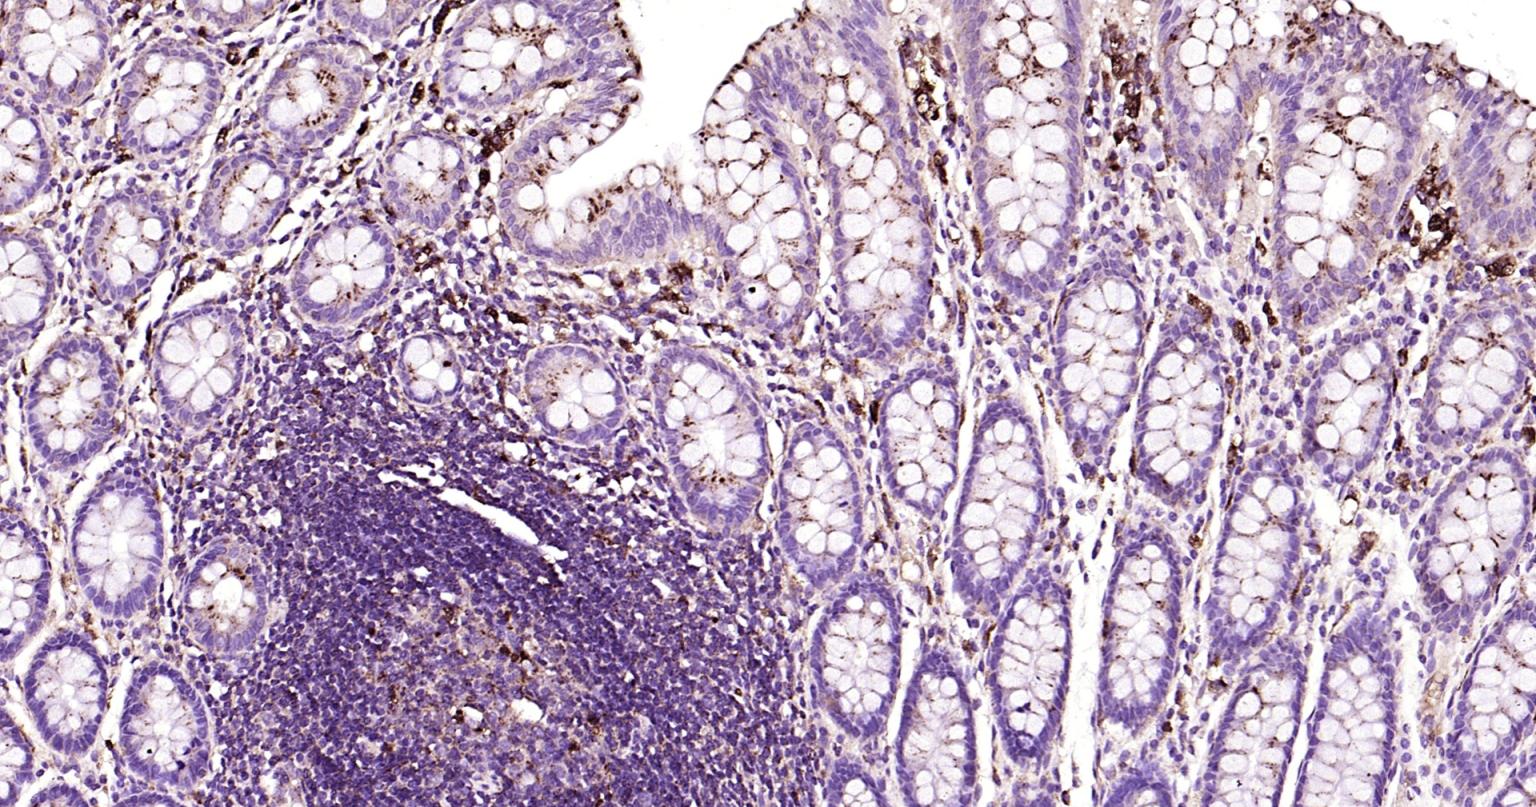
溶酶体相关膜蛋白1（CD107）单克隆抗体-bsm-51301M
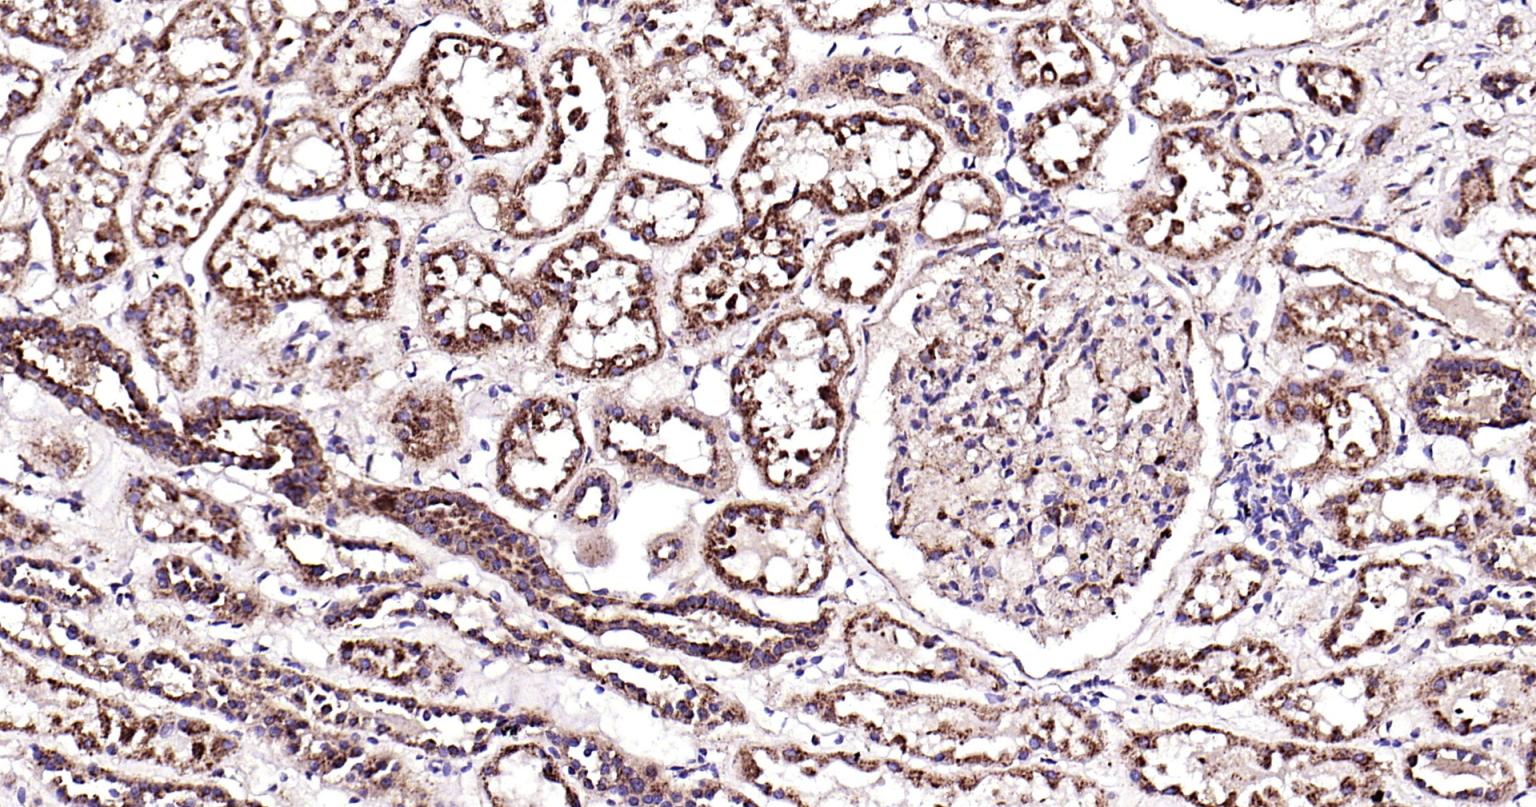
溶酶体相关膜蛋白1（CD107）单克隆抗体-bsm-51301M
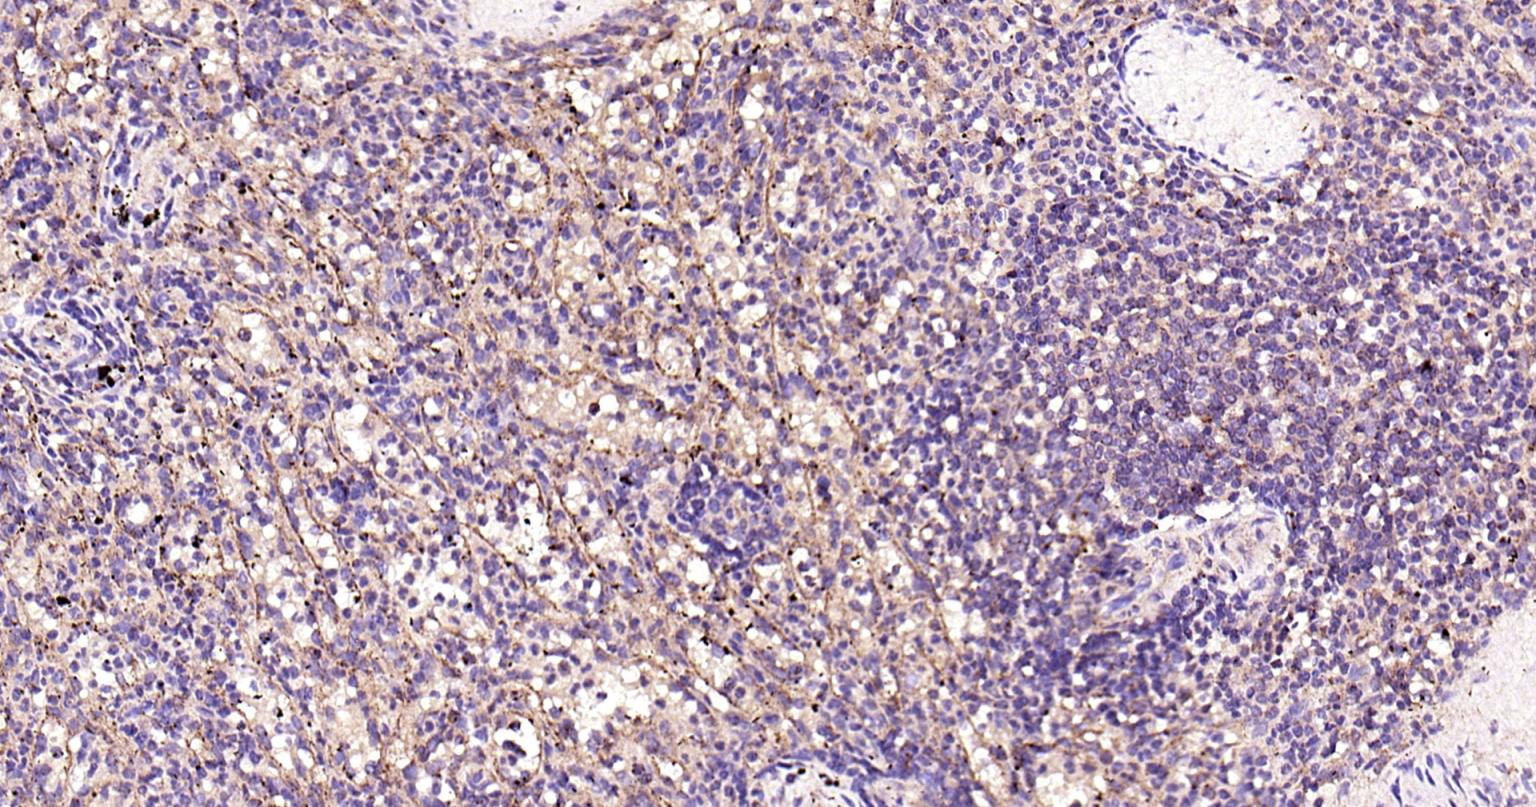
溶酶体相关膜蛋白1（CD107）单克隆抗体-bsm-51301M

Cancer > Cell Death > Autophagy > Signal Transduction
Cancer > Signal transduction > Autophagy
Metabolism > Pathways and Processes > Metabolism processes > Autophagy and mitophagy
Microbiology > Organism > Virus > RNA Virus > ssRNA positive strand virus > SARS Coronavirus
Neuroscience > Cell Type Marker > Neuron marker > Growth Cone
Neuroscience > Cell Type Marker > Neuron marker > Soma marker
Neuroscience > Neurology process > Neurogenesis
Signal Transduction > Antibodies > lamp1
Signal Transduction > Protein Trafficking > Organelle Proteins
Stem Cells > Hematopoietic Progenitors > Lymphoid > B Lymphocytic Lineage
Stem Cells > Hematopoietic Progenitors > Lymphoid > T Lymphocytic Lineage
Stem Cells > Hematopoietic Progenitors > Myeloid > Monocytic Lineage
Tags & Cell Markers > Subcellular Markers > Organelles > Lysosome

| 应用 | 已检合格种属 | 预测种属 | 推荐稀释比例 |
|---|---|---|---|
| WB | Human | 1:500-1000 | |
| IHC-P | Human | 1:100-500 | |
| IHC-F | Human | 1:100-500 | |
| IF | Human | 1:100-500 | |
| Flow-Cyt | Human | 1:100-200 | |
| ICC/IF | Human | 1:50-200 | |
| ELISA | Human | 1:5000-10000 |
交叉反应: Human
暂无相关产品